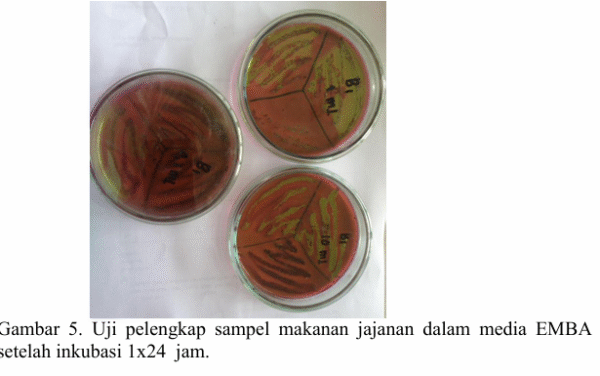

Fikes.umsida.ac.id – Makanan kantin kampus sering kali dianggap sebagai pilihan praktis bagi mahasiswa dan tenaga pendidik.
Namun, sebuah penelitian yang dilakukan oleh Jamilatur Rohmah S Si M Si, Chylen Setiyo Rini S Si M Si dan Siti Cholifah S ST M Keb.
Dosen D4 Teknologi Laboratorium Medis dan S1 Kebidanan Fakultas Ilmu Kesehatan (FIKES) Universitas Muhammadiyah Sidoarjo (Umsida).
Menjelaskan adanya tanda bahaya yang perlu menjadi perhatian bersama.
Dalam riset tersebut, dari 35 sampel makanan jajanan yang diuji, sebanyak 71,43% terdeteksi positif terkontaminasi bakteri Escherichia coli (E. coli).
Baca Juga: Laboran MIK Umsida Torehkan Prestasi Lewat Inovasi Pembelajaran Berbasis Augmented Reality
Angka yang menunjukkan perlunya evaluasi terhadap praktik kebersihan pangan di lingkungan kampus.
Temuan ini terlihat jelas melalui uji perkiraan, penegasan, hingga pelengkap, yang memperlihatkan sebaran kontaminasi pada berbagai jenis jajanan di tiga kantin kampus berbeda.
Kontaminasi Tinggi yang Mengancam Kesehatan
Bakteri E. coli dikenal sebagai indikator sanitasi yang kurang memadai dan dapat menjadi penyebab utama penyakit bawaan makanan.
Seperti diare keluhan kesehatan yang sering dialami mahasiswa.
Pada sejumlah sampel, hasil uji laboratorium menunjukkan pertumbuhan koloni yang tak terhingga, menandakan tingginya beban mikroba pada makanan jajanan.
Kondisi ini dapat meningkatkan risiko gangguan kesehatan apabila jajanan tersebut dikonsumsi secara rutin oleh civitas akademika.
Cek Juga: Gejala Toksisitas Ekstrak Bunga Turi Putih dan Implikasinya untuk Pengobatan Tradisional
Faktor Risiko yang Sering Dianggap Remeh
Penelitian ini mencatat bahwa kontaminasi dapat terjadi pada berbagai titik kritis, mulai dari kebersihan tangan penjamah makanan, kondisi peralatan, kualitas air yang digunakan, hingga sanitasi ruang dapur.
Proses pengolahan yang tidak mengikuti standar kebersihan turut memperburuk risiko kontaminasi.
Pemeriksaan laboratorium menggunakan media LB, BGLB, dan EMBA menunjukkan indikasi kuat keberadaan E. coli.
Yang ditandai dengan terbentuknya gas pada tabung Durham serta koloni hijau metalik pada media kultur.
Penguatan Untuk Meningkatkan Standar Kebersihan
Temuan ini menjadi momentum penting bagi pengelola kantin dan pihak kampus untuk memperkuat sistem keamanan pangan.
Meskipun belum ada laporan kasus keracunan makanan, langkah preventif tetap diperlukan untuk meningkatkan kualitas layanan.
Cek Selengkapnya: 7 Kebiasaan Sederhana untuk Mengurangi Paparan Mikroplastik Menurut Ahli Umsida
Pelatihan rutin bagi penjamah makanan, pemeriksaan sanitasi berkala, hingga penyediaan fasilitas higienis yang memadai dapat memperkuat kepercayaan mahasiswa terhadap kantin kampus.
Sebagai ruang yang mendukung aktivitas harian civitas akademika, kantin memiliki tanggung jawab besar terhadap kesehatan mahasiswa.
Dengan penguatan standar kebersihan dan keamanan pangan, kampus dapat memastikan lingkungan belajar yang lebih sehat, aman, dan berkualitas bagi seluruh warganya.
Sumber: Riset Jamilatur Rohmah S Si M Si & Tim
Penulis: Elfira Armilia























